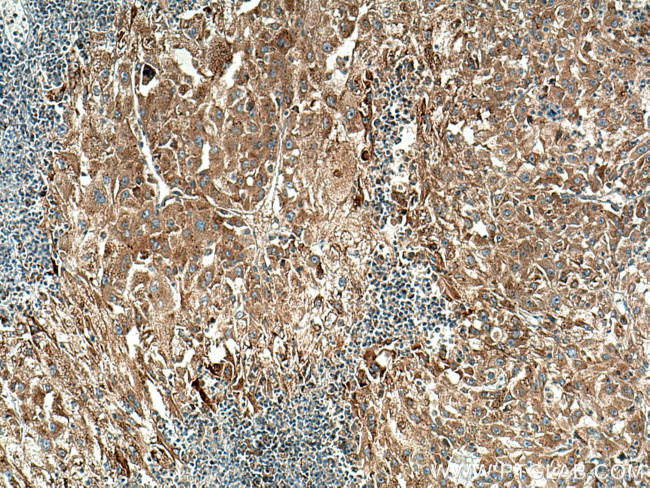
RAB10 Antibody in Immunohistochemistry (Paraffin) (IHC (P))

Search
Proteintech
RAB10 Polyclonal Antibody
{{$productOrderCtrl.translations['antibody.pdp.commerceCard.promotion.promotions']}}
{{$productOrderCtrl.translations['antibody.pdp.commerceCard.promotion.viewpromo']}}
{{$productOrderCtrl.translations['antibody.pdp.commerceCard.promotion.promocode']}}: {{promo.promoCode}} {{promo.promoTitle}} {{promo.promoDescription}}. {{$productOrderCtrl.translations['antibody.pdp.commerceCard.promotion.learnmore']}}
产品信息
11808-1-AP
种属反应
已发表种属
宿主/亚型
分类
类型
抗原
偶联物
形式
浓度
规格
纯化类型
保存液
内含物
保存条件
运输条件
产品详细信息
Immunogen sequence: MAKKTYDLL FKLLLIGDSG VGKTCVLFRF SDDAFNTTFI STIGIDFKIK TVELQGKKIK LQIWDTAGQE RFHTITTSYY RGAMGIMLVY DITNGKSFEN ISKWLRNIDE HANEDVERML LGNKCDMDDK RVVPKGKGEQ IAREHGIRFF ETSAKANINI EKAFLTLAED ILRKTPVKEP NSENVDISSG GGVTGWKSKC C (1-200 aa encoded by BC000896)
靶标信息
RAB10 belongs to the RAS superfamily of small GTPases. RAB proteins localize to exocytic and endocytic compartments and regulate intracellular vesicle trafficking.
仅用于科研。不用于诊断过程。未经明确授权不得转售。
生物信息学
蛋白别名: GTP-binding protein RAB10; RAB10; rab10 GTP-binding protein; ras-related GTP-binding protein; Ras-related protein Rab-10; ras-related protein rab10; unnamed protein product
基因别名: Ac1075; AW107754; RAB10
UniProt ID: (Human) P61026, (Mouse) P61027
Entrez Gene ID: (Dog) 403958, (Human) 10890, (Mouse) 19325, (Rat) 50993